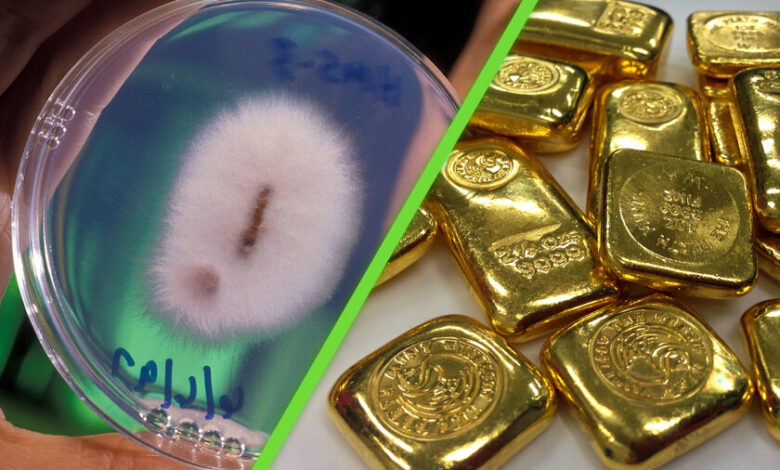

Hemos descubierto hongos que pueden metabolizar el oro; hay quien piensa que son claves para la mineria espacial
En una ciudad llamada Boddington, al sur de la ciudad australiana de Perth, un equipo de investigadores del CSIRO descubrió algo inusual en la naturaleza: algunas cepas del hongo Fusarium oxysporum no solo extraían oro de su entorno, sino que eran capaces de integrarlo en su estructura. Esto, además, les permitía propagarse más rápidamente que otras cepas.
Este comportamiento resulta interesante, ya que si bien es común que los hongos participen en la degradación y el reciclaje de materiales orgánicos —como hojas y cortezas—, así como de ciertos metales como aluminio, hierro, manganeso o calcio, el caso del oro es ligeramente distinto.
De acuerdo con Tsing Bohu, investigador del proyecto, esto se debe a que el oro es químicamente muy inactivo, por lo que este tipo de interacciones son “inusuales y sorprendentes”.
Hongos, oro y exploración minera
Según la publicación de la investigación en Nature Communications, esta es la primera evidencia sólida del papel que juegan los hongos en el ciclo del oro dentro de la corteza terrestre.
Tras darse a conocer esta evidencia, en 2019, la industria minera mostró interés en el hallazgo. Australia es el segundo mayor productor de oro del mundo, pero enfrenta un reto: la falta de nuevos yacimientos amenaza con disminuir su producción rápidamente.

Ante este escenario, se consideró que la investigación del CSIRO podría ayudar a detectar nuevos depósitos. En Australia, las prospecciones suelen enfocarse en bosques de eucaliptos o en zonas con termiteros, ya que ambas áreas están estrechamente relacionadas con la presencia de oro. Por ello, buscar cepas de Fusarium oxysporum en estos entornos resultaba una estrategia prometedora.
Minería metabólica: ¿el futuro de la exploración?
Sin embargo, existe otra ruta para aprovechar estos hongos: la minería metabólica. De acuerdo con Eduardo Bazo, en años recientes han surgido empresas que utilizan organismos para extraer oro.
Aunque este método es más complejo —pues, en teoría, ya se puede identificar la ubicación del metal y extraerlo de forma industrial—, presenta ventajas para entornos donde la minería tradicional no es viable, como el espacio.


En el sistema solar existen vastos depósitos minerales sin explotar. No obstante, además de las limitaciones actuales, uno de los grandes retos es procesar los metales en el espacio.
La minería metabólica plantea una solución: enviar cepas modificadas de hongos, o de otros microorganismos, que sean capaces de procesar los minerales de forma autónoma, facilitando su extracción. Aunque no necesariamente sería un método barato o inmediato, representa una opción con potencial.
Por ahora, ya existen distintos esfuerzos para cultivar microorganismos capaces de procesar oro. Si bien puede parecer una propuesta extraña, enfoques similares ya se han aplicado con éxito en productos cotidianos.
DERECHOS DE AUTOR
Esta información pertenece a su autor original y fue recopilada del sitio https://www.xataka.com.mx/investigacion/hemos-descubierto-hongos-que-pueden-metabolizar-oro-hay-quien-piensa-que-claves-para-mineria-espacial




